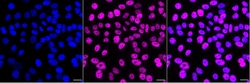
Invitrogen MBD2 Recombinant Rabbit Monoclonal Antibody (24GB4570) 20 &mu;L;

missing translation for 'onlineSavingsMsg'
Learn More
Learn More
Invitrogen™ MBD2 Recombinant Rabbit Monoclonal Antibody (24GB4570)
Rabbit Recombinant Monoclonal Antibody
Brand: Invitrogen™ MA557475
This item is not returnable.
View return policy
Description
MBD2 Recombinant Monoclonal Antibody for Western Blot, Flow
Heterochromatin protein-1 (HP1) is a methyl-lysine binding protein localized at heterochromatin sites, where it mediates gene silencing. It has been shown that mammalian methyltransferases that selectively methylate histone H3 on lysine-9 generate a binding site for HP1 proteins, a family of heterochromatic adaptor molecules implicated in both gene silencing and supranucleosomal chromatin structure. High-affinity in vitro recognition of a methylated histone H3 peptide by HP1 requires a functional chromodomain. Thus, the HP1 chromodomain is a specific interaction motif for the methyl epitope on lysine-9 of histone H3. In vivo, heterochromatin association of HP1 proteins is lost in Suv39h double-null primary mouse fibroblasts but is restored after reintroduction of a catalytically active SUV39H1 HMTase.
Specifications
| MBD2 | |
| Recombinant Monoclonal | |
| Unconjugated | |
| Mbd2 | |
| demethylase; DKFZp586O0821; DMTase; MBD2; MBD2a; methyl-CpG binding domain protein 2; methyl-CpG-binding domain protein 2; Methyl-CpG-binding protein MBD2; NY-CO-41 | |
| Rabbit | |
| Affinity chromatography | |
| RUO | |
| 17191, 680172, 8932 | |
| -20°C | |
| Liquid |
| Flow Cytometry, Western Blot, Immunocytochemistry | |
| 24GB4570 | |
| PBS with 50% glycerol and 0.02% sodium azide; pH 7.4 | |
| Q9UBB5, Q9Z2E1 | |
| Mbd2 | |
| A synthesized peptide derived from human MBD2 (aa 216-234). | |
| 20 μL | |
| Primary | |
| Human, Mouse, Rat | |
| Antibody | |
| IgG |
Product Content Correction
Your input is important to us. Please complete this form to provide feedback related to the content on this product.
Product Title
Spot an opportunity for improvement?Share a Content Correction